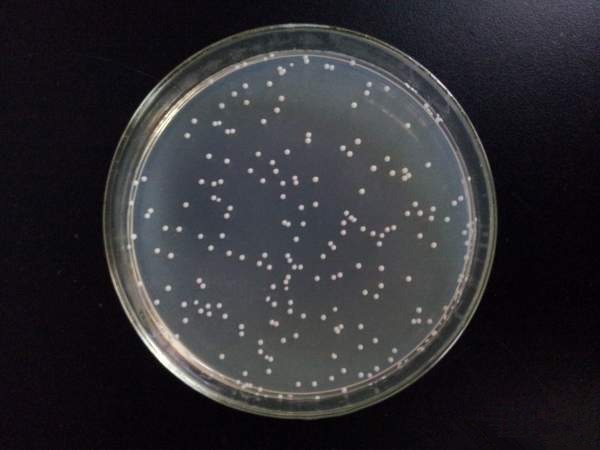
escherichia coli

escherichia细菌

展开全部 埃希氏菌属拉丁学名(escherichia castellani and chalmers
图片尺寸400x268
ppt 很全,值得学微生物的童鞋收藏 第一节 埃希菌属 (escherichia)
图片尺寸1080x810
escherichia coli
图片尺寸500x281
分为5类:肠道致病性大肠埃希氏菌(enteropathogenic escherichiacoli
图片尺寸517x347
大肠埃希氏菌(escherichia coli) 简称为大肠杆菌,是最为著名的原核
图片尺寸596x495
细菌染色法 | 生物学竞赛辞典 维基 | fandom
图片尺寸1310x1517
粗略的回答下吧 大肠杆菌(学名:escherichia coli,通常简写为e.
图片尺寸600x402
重复发帖 违规侵权,站友争执 附件异常,链接失效 其他 escherichia
图片尺寸560x420
大肠埃希氏菌(escherichia coli)
图片尺寸500x342
大肠埃希氏菌o157h7nm检验解析常规培养法
图片尺寸300x300
肠炎等肠道疾病的大肠杆菌,学名大肠埃舍里希氏菌( escherichia coli
图片尺寸960x694
从全基因组角度上,大肠埃希菌(escherichia coli,e.
图片尺寸900x712
东北农业大学孔保华教授等光动力灭活在食品杀菌保鲜中的研究进展
图片尺寸700x359
nobacter hydrossishalanaerobium praevalens大肠杆菌 escherichia
图片尺寸576x440
atcc baa-2340 大肠埃希氏菌,escherichia coli
图片尺寸360x288
库存插图-escherichia, 在下面, 细菌, 显微镜
图片尺寸450x282
肠道细菌:大肠杆菌(escherichia coli)
图片尺寸468x312
escherichia coli
图片尺寸600x450
埃希氏菌属拉丁学名(escherichia castellani and chalmers,1919) 直
图片尺寸220x165
伊红美蓝培养基emb的应用
图片尺寸350x284